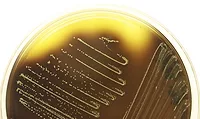

Scientists Discover Antibodies That Could Lead to Broadly Effective Norovirus Vaccine

Image credit: kjpargeter via Freepik
Scientists have recently discovered antibodies that can neutralize a wide range of norovirus strains, which could lead to the development of a broadly effective vaccine for the foodborne pathogen, as well as new therapeutic antibodies for treating gastroenteritis caused by norovirus.
Norovirus is a significant cause of foodborne illness and is commonly spread by ill employees at restaurant and foodservice establishments; according to the latest data from the U.S. Centers for Disease Control and Prevention (CDC), most foodborne viral outbreaks are caused by contamination from ill food workers. Norovirus itself infects more than 700 million people each year, causing “stomach bug”-like symptoms, such as vomiting and diarrhea.
Historically, the development of a norovirus vaccine has been challenging due to its many genetic variants and frequent mutation, enabling the virus to evade herd immunity—a phenomenon that has been seen in the UK during the winter 2024–spring 2025 season. A new study, however, provides insights into how the immune system responds to norovirus and paves the way for designing a vaccine that offers broad, long-lasting protection.
The research, published in Science Translational Medicine, was led by scientists at the University of Texas at Austin (UT Austin), in collaboration with scientists at the University of North Carolina at Chapel Hill and the U.S. National Institutes of Health (NIH).
Using advanced molecular analysis, the researchers studied the immune responses of participants who received an experimental oral norovirus vaccine developed by Vaxart. The team discovered that some individuals produced antibodies that not only broadly neutralized multiple norovirus strains, including both historical and emerging variants, but also cross-neutralized multiple types of norovirus responsible for approximately 75 percent of global norovirus outbreaks.
One antibody identified in the study, VX22, targets a previously undiscovered vulnerability in the virus' structure, and is able to neutralize noroviruses from multiple genotypes by binding to a highly conserved region in the virus particles, making it a strong candidate for vaccine development.
The newly found antibodies could also be used to develop a treatment for infected people who are immunocompromised and therefore unable to fight off illness on their own.
Looking for quick answers on food safety topics?
Try Ask FSM, our new smart AI search tool.
Ask FSM →
The research team is now working on refining the design for a vaccine and testing the relevance of these findings in broader populations, such as among elderly people and young children. Several of the study’s authors have filed patent applications on some of the broadly neutralizing antibodies identified through their research.
Funding for the study was provided by the NIH National Institute of Allergy and Infectious Disease, the Dutch Research Council, the Institute for Chemical Immunology, and the NIH Vaccine Research Center. The work was led by George Georgiou, Ph.D., co-corresponding author, and UT Austin Professor of Molecular Biosciences and Dula D. Cockrell Centennial Chair in Engineering in the McKetta Department of Chemical Engineering; as well as Juyeon Park, first author and Postdoctoral Fellow at UT Austin.